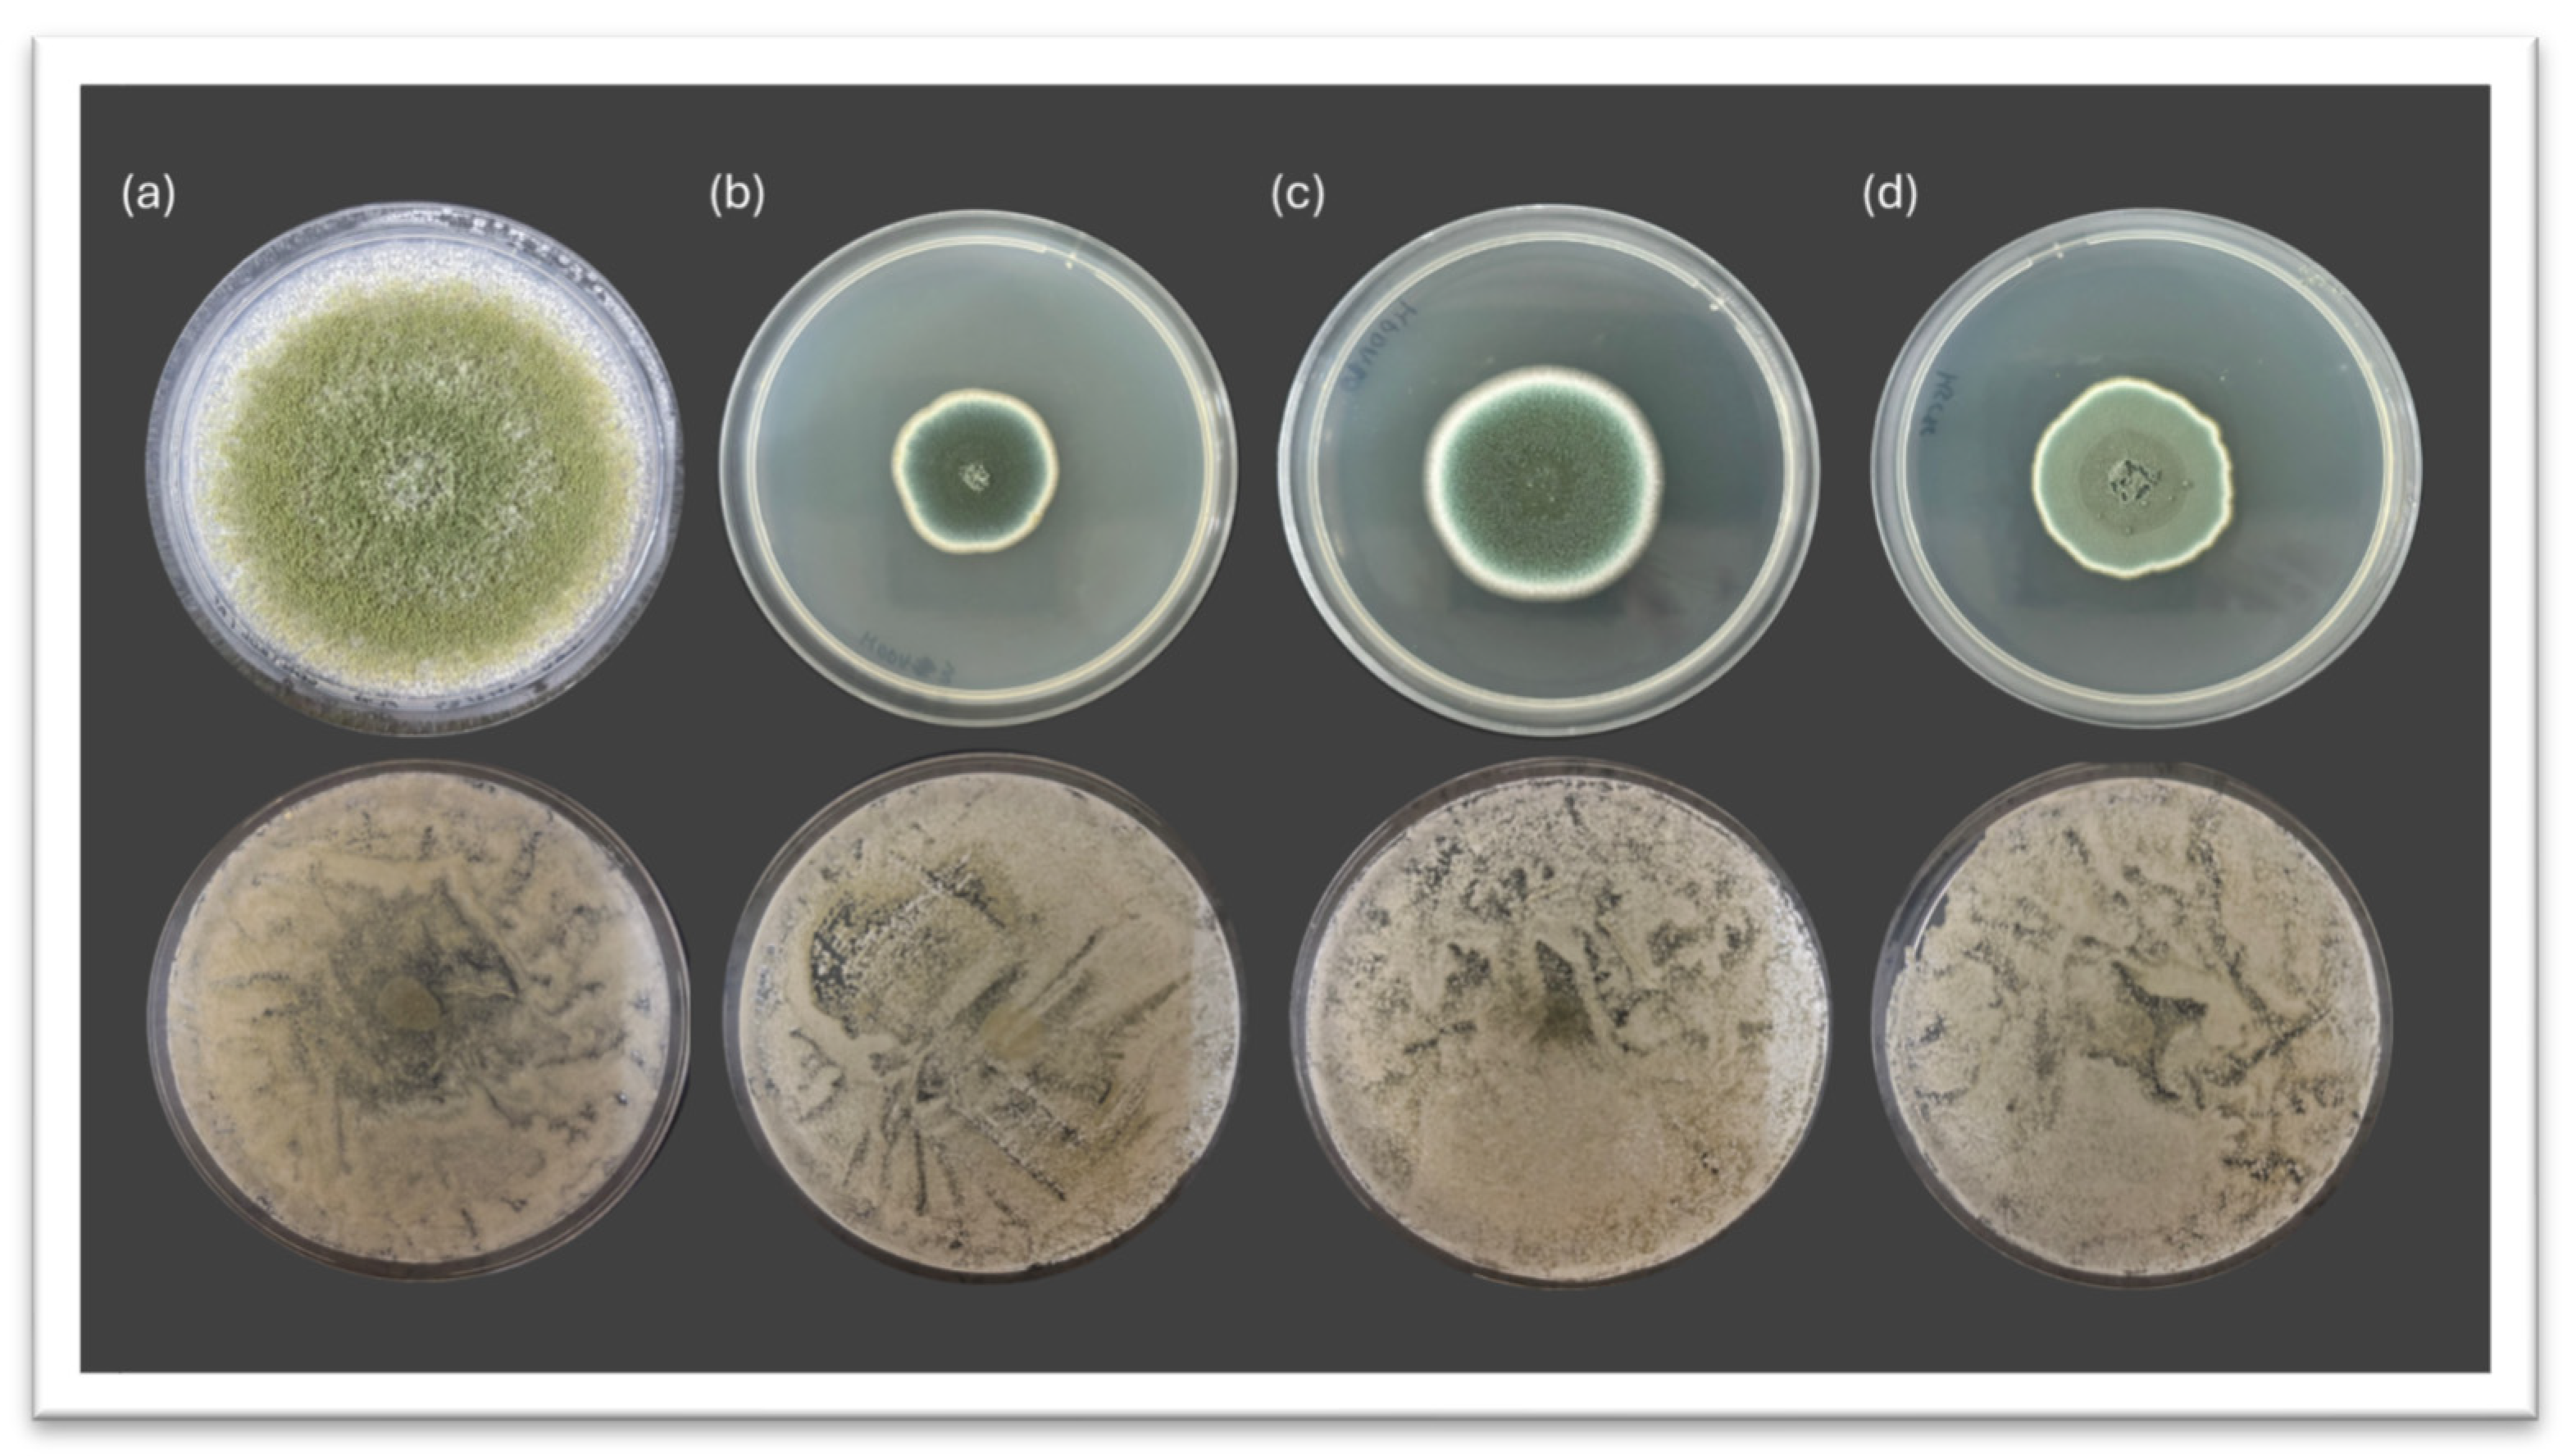
Jof 11 00681 g001
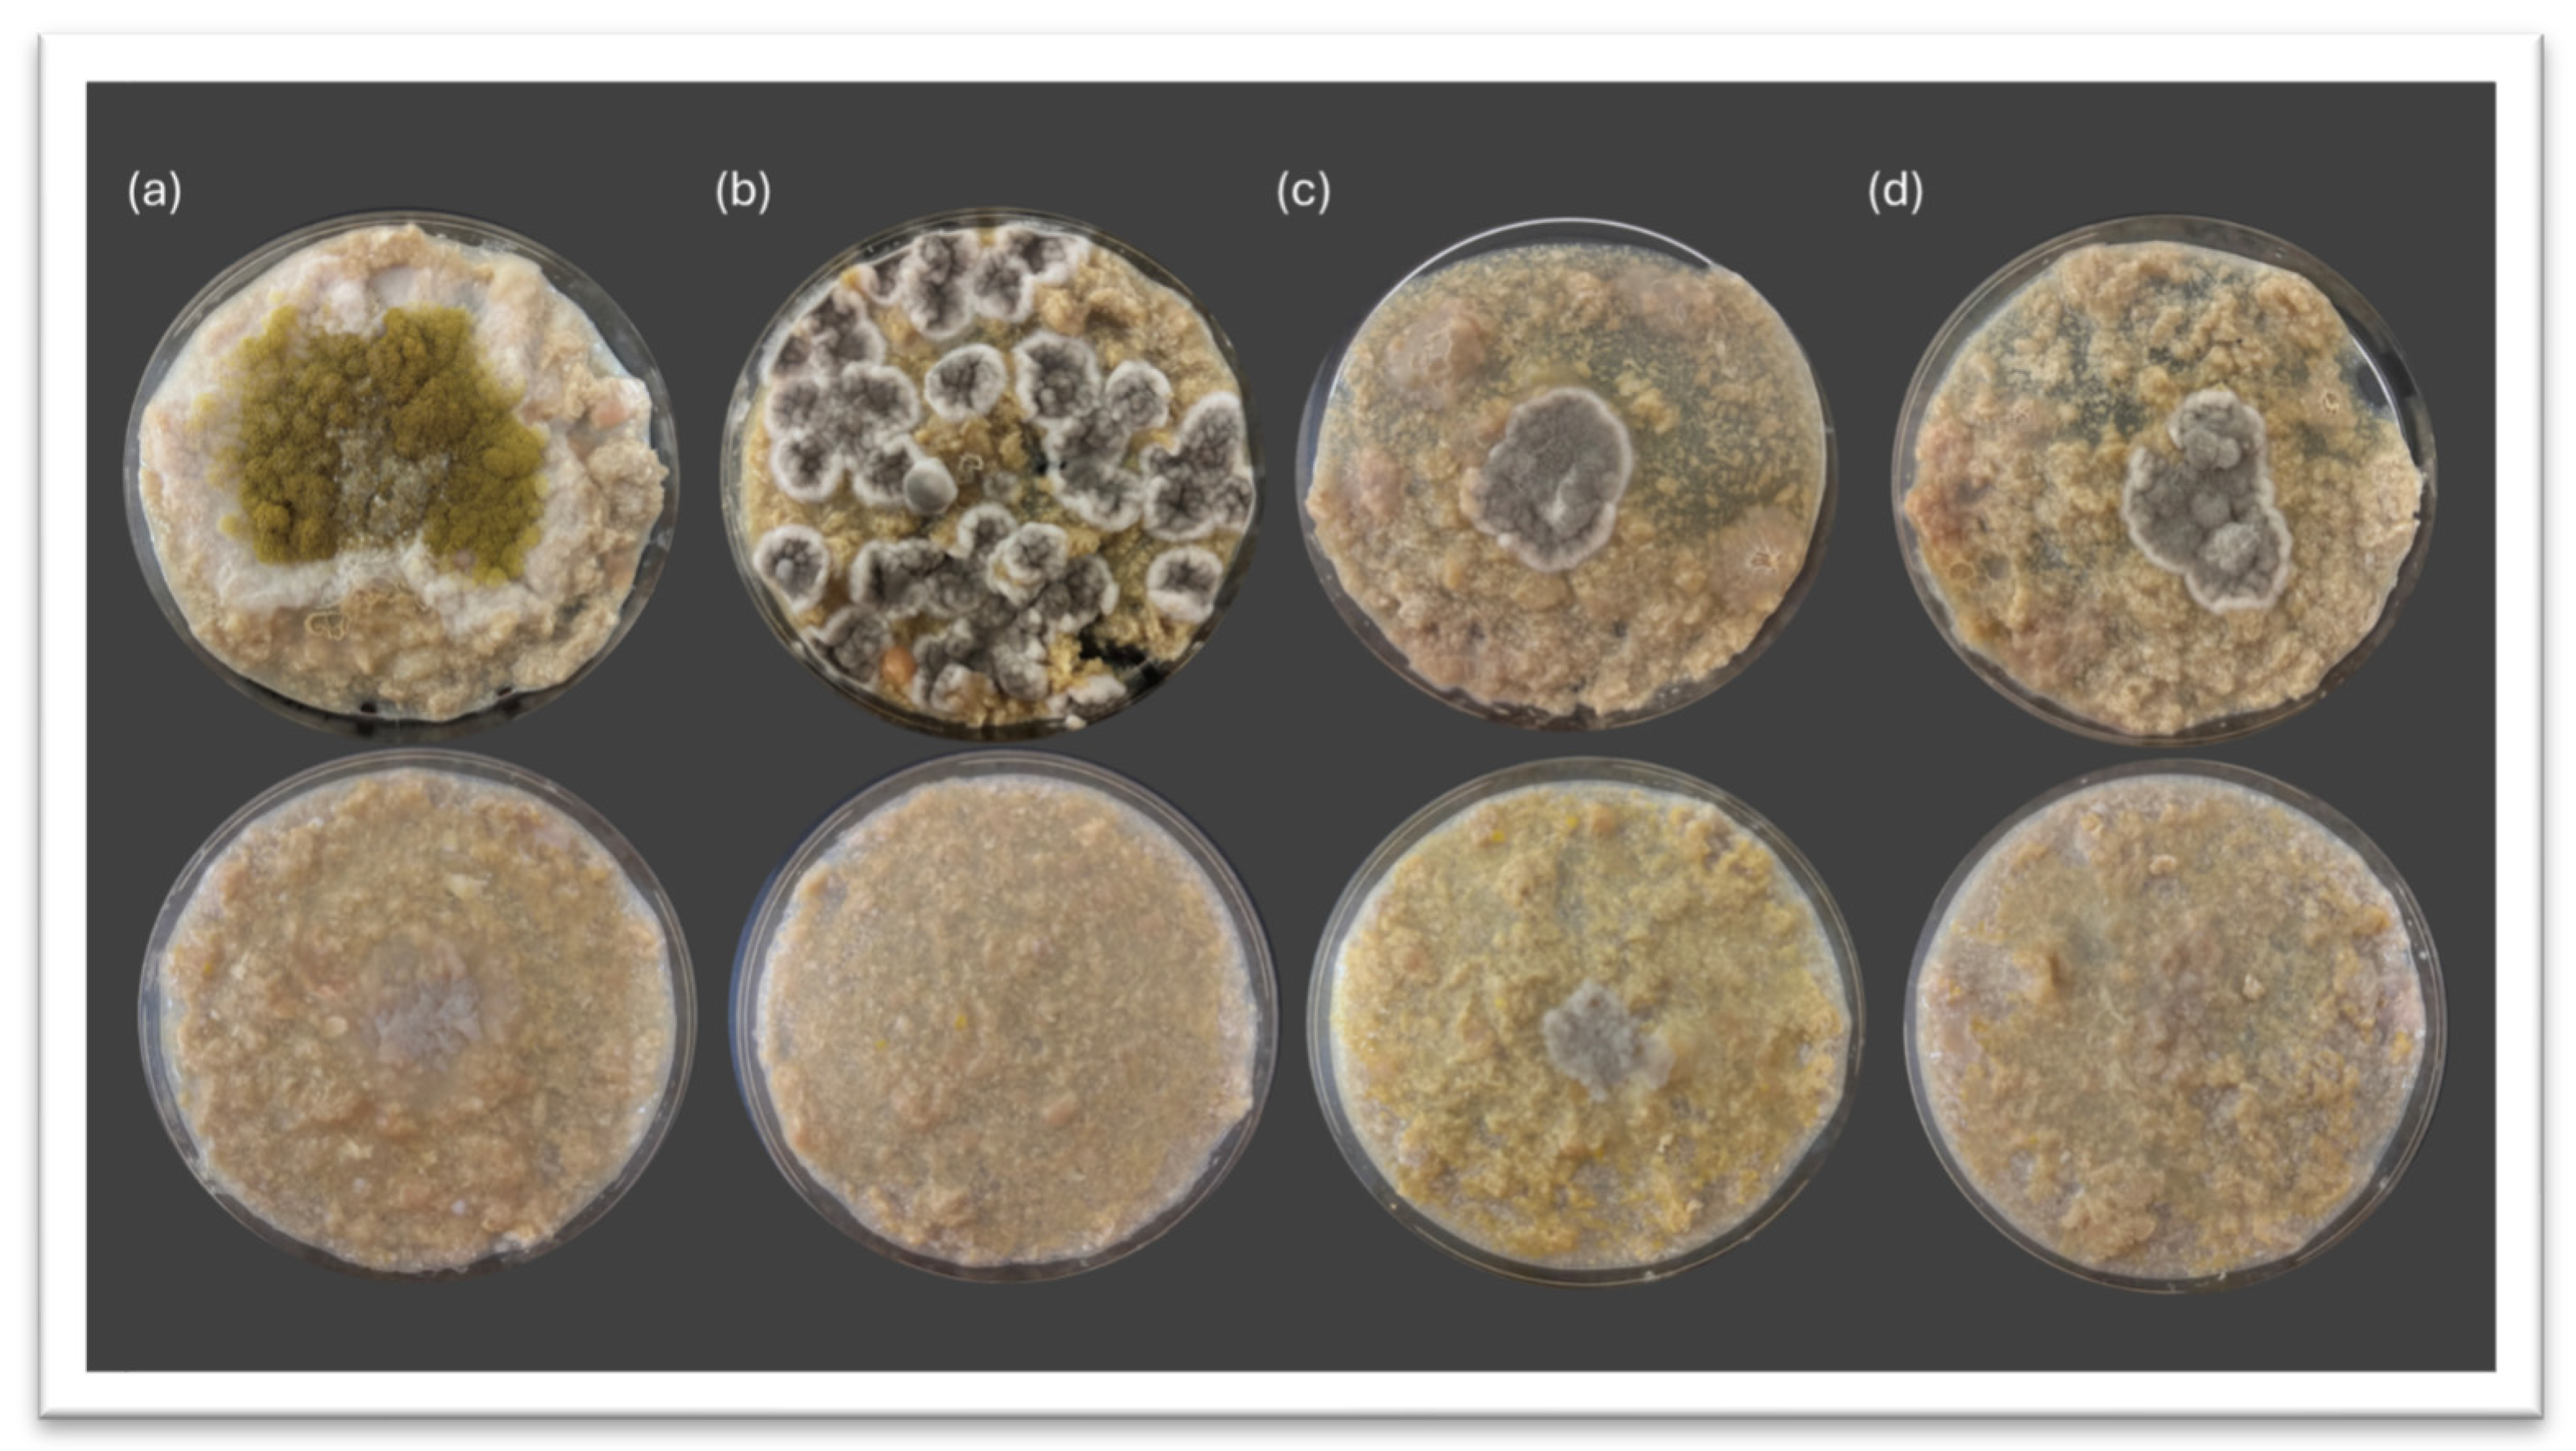
Jof 11 00681 g003

Assessing the Biocontrol Activity of Debaryomyces hansenii Against Spoilage Molds in Synthetic and Meat-Derived Media
Abstract
1. Introduction
2. Materials and Methods
2.1. Biological Material and Culture Conditions
2.2. Evaluation of the Antifungal Potential of D. hansenii Against Undesirable Molds
2.3. Data Quantification and Statistical Analysis
3. Results
3.1. Inhibitory Potential of Debaryomyces hansenii Against Spoilage Molds on PDA Media
3.2. Inhibitory Potential of Debaryomyces hansenii Against Spoilage Molds on Meat-Derived Media
3.3. Influence of the Culture Medium on the Antifungal Performance of Debaryomyces hansenii
4. Discussion
5. Conclusions
Author Contributions
Funding
Institutional Review Board Statement
Informed Consent Statement
Data Availability Statement
Acknowledgments
Conflicts of Interest
References
- Núñez, F.; Lara, M.S.; Peromingo, B.; Delgado, J.; Sánchez-Montero, L.; Andrade, M.J. Selection and evaluation of Debaryomyces hansenii isolates as potential bioprotective agents against toxigenic penicillia in dry-fermented sausages. Food Microbiol. 2015, 46, 114–120. [Google Scholar] [CrossRef]
- Freimoser, F.M.; Rueda-Mejia, M.P.; Tilocca, B.; Migheli, Q. Biocontrol yeasts: Mechanisms and applications. World J. Microbiol. Biotechnol. 2019, 35, 154. [Google Scholar] [CrossRef]
- Chen, O.; Hong, Y.; Ma, J.; Deng, L.; Yi, L.; Zeng, K. Screening lactic acid bacteria from pickle and cured meat as biocontrol agents of Penicillium digitatum on citrus fruit. Biol. Control 2021, 158, 104606. [Google Scholar] [CrossRef]
- Chacón-Navarrete, H.; Ruiz-Pérez, F.; Ruiz-Castilla, F.J.; Ramos, J. Exploring Biocontrol of Unwanted Fungi by Autochthonous Debaryomyces hansenii Strains Isolated from Dry Meat Products. J. Fungi 2022, 8, 873. [Google Scholar] [CrossRef]
- Sipiczki, M. Identification of antagonistic yeasts as potential biocontrol agents: Diverse criteria and strategies. Int. J. Food Microbiol. 2023, 406, 110360. [Google Scholar] [CrossRef] [PubMed]
- Medina-Córdova, N.; López-Aguilar, R.; Ascencio, F.; Castellanos, T.; Campa-Córdova, A.I.; Angulo, C. Biocontrol activity of the marine yeast Debaryomyces hansenii against phytopathogenic fungi and its ability to inhibit mycotoxins production in maize grain (Zea mays L.). Biol. Control 2016, 97, 70–79. [Google Scholar] [CrossRef]
- Medina-Córdova, N.; Rosales-Mendoza, S.; Hernández-Montiel, L.G.; Angulo, C. The potential use of Debaryomyces hansenii for the biological control of pathogenic fungi in food. Biol. Control 2018, 121, 216–222. [Google Scholar] [CrossRef]
- Kowalska, J.; Krzymińska, J.; Tyburski, J. Yeasts as a Potential Biological Agent in Plant Disease Protection and Yield Improvement—A Short Review. Agriculture 2022, 12, 1404. [Google Scholar] [CrossRef]
- Huang, C.; Zhang, L.; Johansen, P.G.; Petersen, M.A.; Arneborg, N.; Jespersen, L. Debaryomyces hansenii Strains Isolated From Danish Cheese Brines Act as Biocontrol Agents to Inhibit Germination and Growth of Contaminating Molds. Front. Microbiol. 2021, 12, 662785. [Google Scholar] [CrossRef]
- Ramos, J.; Melero, Y.; Ramos-Moreno, L.; Michán, C.; Cabezas, L. Debaryomyces hansenii Strains from Valle De Los Pedroches Iberian Dry Meat Products: Isolation, Identification, Characterization, and Selection for Starter Cultures. J. Microbiol. Biotechnol. 2017, 27, 1576–1585. [Google Scholar] [CrossRef]
- Belloch, C.; Perea-Sanz, L.; Gamero, A.; Flores, M. Selection of Debaryomyces hansenii isolates as starters in meat products based on phenotypic virulence factors, tolerance to abiotic stress conditions and aroma generation. J. Appl. Microbiol. 2022, 133, 200–211. [Google Scholar] [CrossRef]
- Prista, C.; Almagro, A.; Loureiro-Dias, M.C.; Ramos, J. Physiological basis for the high salt tolerance of Debaryomyces hansenii. Appl. Environ. Microbiol. 1997, 63, 4005–4009. [Google Scholar] [CrossRef]
- Michán, C.; Martínez, J.L.; Alvarez, M.C.; Turk, M.; Sychrova, H.; Ramos, J. Salt and oxidative stress tolerance in Debaryomyces hansenii and Debaryomyces fabryi. FEMS Yeast Res. 2013, 13, 180–188. [Google Scholar] [CrossRef]
- Corral, S.; Salvador, A.; Belloch, C.; Flores, M. Effect of fat and salt reduction on the sensory quality of slow fermented sausages inoculated with Debaryomyces hansenii yeast. Food Control 2014, 45, 1–7. [Google Scholar] [CrossRef]
- Prista, C.; Michán, C.; Miranda, I.M.; Ramos, J. The halotolerant Debaryomyces hansenii, the Cinderella of non-conventional yeasts. Yeast 2016, 33, 523–533. [Google Scholar] [CrossRef]
- Ruiz-Pérez, F.S.; Ruiz-Castilla, F.J.; Leal, C.; Martínez, J.L.; Ramos, J. Sodium and lithium exert differential effects on the central carbon metabolism of Debaryomyces hansenii through the glyoxylate shunt regulation. Yeast 2023, 40, 265–275. [Google Scholar] [CrossRef]
- Chacón-Navarrete, H.; Gómez, M.; Cardador, M.J.; Salatti-Dorado, J.Á.; Pérez-Cacho, P.R.; Roldán-Casas, J.Á.; Arce, L.; Galán-Soldevilla, H.; López, B.; Ramos, J.; et al. The antimycotic potential of Debaryomyces hansenii LRC2 on Iberian Pork Loins with low concentration preservatives. Food Control 2024, 165, 110632. [Google Scholar] [CrossRef]
- Ochoa-Gutiérrez, D.; Reyes-Torres, A.M.; de la Fuente-Colmenares, I.; Escobar-Sánchez, V.; González, J.; Ortiz-Hernández, R.; Torres-Ramírez, N.; Segal-Kischinevzky, C. Alternative CUG Codon Usage in the Halotolerant Yeast Debaryomyces hansenii: Gene Expression Profiles Provide New Insights into Ambiguous Translation. J. Fungi 2022, 8, 970. [Google Scholar] [CrossRef] [PubMed]
- Lépingle, A.; Casaregola, S.; Neuvéglise, C.; Bon, E.; Nguyen, H.; Artiguenave, F.; Wincker, P.; Gaillardin, C. Genomic exploration of the hemiascomycetous yeasts: 14. Debaryomyces hansenii var. hansenii. FEBS Lett. 2000, 487, 82–86. [Google Scholar] [CrossRef] [PubMed]
- Petersen, K.M.; Jespersen, L. Genetic diversity of the species Debaryomyces hansenii and the use of chromosome polymorphism for typing of strains isolated from surface-ripened cheeses. J. Appl. Microbiol. 2004, 97, 205–213. [Google Scholar] [CrossRef]
- Jacques, N.; Sacerdot, C.; Derkaoui, M.; Dujon, B.; Ozier-Kalogeropoulos, O.; Casaregola, S. Population polymorphism of nuclear mitochondrial DNA insertions reveals widespread diploidy associated with loss of heterozygosity in Debaryomyces hansenii. Eukaryot. Cell 2010, 9, 449–459. [Google Scholar] [CrossRef]
- Chacón-Navarrete, H.; García-Álvarez de Toledo, I.; Ramos, J.; Ruiz-Castilla, F.J. Evaluating the Role of Nutrient Competition in Debaryomyces hansenii Biocontrol Activity Against Spoilage Molds in the Meat Industry. J. Fungi 2025, 11, 242. [Google Scholar] [CrossRef] [PubMed]
- EFSA Panel on Biological Hazards (BIOHAZ); Koutsoumanis, K.; Allende, A.; Alvarez-Ordóñez, A.; Bolton, D.; Bover-Cid, S.; Chemaly, M.; De Cesare, A.; Hilbert, F.; Lindqvist, R.; et al. Update of the list of qualified presumption of safety (QPS) recommended microbiological agents intentionally added to food or feed as notified to EFSA 17: Suitability of taxonomic units notified to EFSA until September 2022. EFSA J. 2023, 21, e07746. [Google Scholar] [CrossRef]
- Hernández-Montiel, L.G.; Larralde-Corona, C.P.; Vero, S.; López-Aburto, M.G.; Ochoa, J.L.; Ascencio-Valle, F. Characterization of yeast Debaryomyces hansenii for the biological control of blue mold decay of Mexican lemon. CyTA—J. Food 2010, 8, 49–56. [Google Scholar] [CrossRef]
- Iacumin, L.; Manzano, M.; Andyanto, D.; Comi, G. Biocontrol of ochratoxigenic moulds (Aspergillus ochraceus and Penicillium nordicum) by Debaryomyces hansenii and Saccharomycopsis fibuligera during speck production. Food Microbiol. 2017, 62, 188–195. [Google Scholar] [CrossRef]
- Andrade, M.J.; Delgado, J.; Rodríguez, M.; Núñez, F.; Córdoba, J.J.; Peromingo, B. Mycotoxins in meat products. Meat Sci. 2025, 227, 109850. [Google Scholar] [CrossRef]
- Banjara, N.; Nickerson, K.W.; Suhr, M.J.; Hallen-Adams, H.E. Killer toxin from several food-derived Debaryomyces hansenii strains effective against pathogenic Candida yeasts. Int. J. Food Microbiol. 2016, 222, 23–29. [Google Scholar] [CrossRef]
- Al-Qaysi, S.A.S.; Al-Haideri, H.; Thabit, Z.A.; Al-Kubaisy, W.H.A.A.; Ibrahim, J.A.A. Production, Characterization, and Antimicrobial Activity of Mycocin Produced by Debaryomyces hansenii DSMZ70238. Int. J. Microbiol. 2017, 2017, 2605382. [Google Scholar] [CrossRef]
- Çorbacı, C.; Uçar, F.B. Purification, characterization and in vivo biocontrol efficiency of killer toxins from Debaryomyces hansenii strains. Int. J. Biol. Macromol. 2018, 119, 1077–1082. [Google Scholar] [CrossRef]
- Połomska, X.; Neuvéglise, C.; Zyzak, J.; Żarowska, B.; Casaregola, S.; Lazar, Z. New Cytoplasmic Virus-Like Elements (VLEs) in the Yeast Debaryomyces hansenii. Toxins 2021, 13, 615. [Google Scholar] [CrossRef]
- Peromingo, B.; Núñez, F.; Rodríguez, A.; Alía, A.; Andrade, M.J. Potential of yeasts isolated from dry-cured ham to control ochratoxin A production in meat models. Int. J. Food Microbiol. 2018, 268, 73–80. [Google Scholar] [CrossRef] [PubMed]
- Breuer, U.; Harms, H. Debaryomyces hansenii—An extremophilic yeast with biotechnological potential. Yeast 2006, 23, 415–437. [Google Scholar] [CrossRef]
- Connelly, S.; Shin, S.G.; Dillon, R.J.; Ijaz, U.Z.; Quince, C.; Sloan, W.T.; Collins, G. Bioreactor Scalability: Laboratory-Scale Bioreactor Design Influences Performance, Ecology, and Community Physiology in Expanded Granular Sludge Bed Bioreactors. Front. Microbiol. 2017, 8, 664. [Google Scholar] [CrossRef]
- Zieringer, J.; Takors, R. In Silico Prediction of Large-Scale Microbial Production Performance: Constraints for Getting Proper Data-Driven Models. Comput. Struct. Biotechnol. J. 2018, 16, 246–256. [Google Scholar] [CrossRef] [PubMed]
- Miyake, D.; Kanaya, S.; Ono, N. Statistical Modeling of Within-Laboratory Precision Using a Hierarchical Bayesian Approach. J. AOAC Int. 2024, 107, 960–970. [Google Scholar] [CrossRef] [PubMed]
- Devi, K.S.; Misra, D.K.; Saha, J.; Devi, P.S.; Sinha, B. Screening of Suitable Culture Media for Growth, Cultural and Morphological Characters of Pycnidia Forming Fungi. Int. J. Curr. Microbiol. App. Sci. 2018, 7, 4207–4214. [Google Scholar] [CrossRef]
- Permadi, M.A.; Mukhlis; Samosir, B.S.; Siregar, D.Y.; Wayni, M. Physiology Characterization of Entomopathogenic Fungi Beauveria bassiana and Metarhizium anisopliae on Different Carbohydrate Sources. J. Phys. Conf. Ser. 2020, 1477, 072007. [Google Scholar] [CrossRef]
- Dzhagan, V.; Krupodorova, T.; Atamanchuk, A.; Lytvynenko, Y.; Dzhagan, V. Growth and morphological characteristics of some pyrophilous discomycetes in culture. Biosyst. Divers. 2023, 31, 282–289. [Google Scholar] [CrossRef]
- Kumar, M.; Ratan, V.; Chaurasiya, A.; Singh, V.; Kumar, N.; Singh, P.; Pratap, G.; Verma, B. In-vitro assessment of different culture of media on the isolation and purification of cauliflower alternaria leaf spot disease caused by Alternaria brassicicola (Schwein). Int. J. Plant Sci. 2023, 35, 1060–1068. [Google Scholar] [CrossRef]
- Cheng, C.-Y.; Zhang, M.-Y.; Niu, Y.-C.; Zhang, M.; Geng, Y.-H.; Deng, H. Comparison of fungal genera isolated from cucumber plants and rhizosphere soil by using various cultural media. J. Fungi 2023, 9, 934. [Google Scholar] [CrossRef]
- Zhang, F.; Li, M.; Tian, J.; Ge, X.; Li, S.; Chen, J.; Li, Y.; Zhang, Y. Isolation and identification of spoilage fungi in potato fresh wet vermicelli and inhibition effect of different fungicides on spoilage fungi. J. Fungi 2025, 11, 367. [Google Scholar] [CrossRef] [PubMed]
- García-Bramasco, C.A.; Blancas-Benitez, F.J.; Montaño-Leyva, B.; Medrano-Castellón, L.M.; Gutierrez-Martinez, P.; González-Estrada, R.R. Influence of marine yeast Debaryomyces hansenii on antifungal and physicochemical properties of chitosan-based films. J. Fungi 2022, 8, 369. [Google Scholar] [CrossRef] [PubMed]
- Peromingo, B.; Rodríguez, A.; Bernáldez, V.; Delgado, J.; Rodríguez, M. Effect of temperature and water activity on growth and aflatoxin production by Aspergillus flavus and Aspergillus parasiticus on cured meat model systems. Meat Sci. 2016, 122, 76–83. [Google Scholar] [CrossRef]
- Peromingo, B.; Andrade, M.J.; Delgado, J.; Sánchez-Montero, L.; Núñez, F. Biocontrol of aflatoxigenic Aspergillus parasiticus by native Debaryomyces hansenii in dry-cured meat products. Food Microbiol. 2019, 82, 269–276. [Google Scholar] [CrossRef]

| Microorganism | Strain | Reference |
|---|---|---|
| D. hansenii | CBS767 (Wild type reference) | [12] |
| D. hansenii | LR2 | [10] |
| D. hansenii | SRF1 | [10] |
| D. hansenii | CB1 | [10] |
| Aspergillus flavus | HSC31 | [22] |
| Penicillium echinulatum | HPDA3 | [22] |
| Penicillium rubens | HPDA10 | [22] |
| Penicillium crustosum | HSC30 | [22] |
| Factor/Interaction | df | F-Value | p-Value |
|---|---|---|---|
| Medium | 1 | 80.667 | <0.001 |
| Yeast strain | 3 | 1.579 | 0.204 |
| Mold | 3 | 46.268 | <0.001 |
| Medium × yeast strain | 3 | 3.165 | 0.031 |
| Medium × mold | 3 | 35.385 | <0.001 |
| Yeast strain × mold | 9 | 1.473 | 0.179 |
| Medium × yeast strain × mold | 9 | 4.066 | 0.001 |
Disclaimer/Publisher’s Note: The statements, opinions and data contained in all publications are solely those of the individual author(s) and contributor(s) and not of MDPI and/or the editor(s). MDPI and/or the editor(s) disclaim responsibility for any injury to people or property resulting from any ideas, methods, instructions or products referred to in the content. |
© 2025 by the authors. Licensee MDPI, Basel, Switzerland. This article is an open access article distributed under the terms and conditions of the Creative Commons Attribution (CC BY) license (https://creativecommons.org/licenses/by/4.0/).
Share and Cite
Ruiz-Castilla, F.J.; Pérez-Fernández, A.L.; Villamagua-Rojas, P.I.; Chacón-Navarrete, H.; Ramos, J. Assessing the Biocontrol Activity of Debaryomyces hansenii Against Spoilage Molds in Synthetic and Meat-Derived Media. J. Fungi 2025, 11, 681. https://doi.org/10.3390/jof11090681
Ruiz-Castilla FJ, Pérez-Fernández AL, Villamagua-Rojas PI, Chacón-Navarrete H, Ramos J. Assessing the Biocontrol Activity of Debaryomyces hansenii Against Spoilage Molds in Synthetic and Meat-Derived Media. Journal of Fungi. 2025; 11(9):681. https://doi.org/10.3390/jof11090681
Chicago/Turabian StyleRuiz-Castilla, Francisco J., Ana L. Pérez-Fernández, Pablo I. Villamagua-Rojas, Helena Chacón-Navarrete, and José Ramos. 2025. "Assessing the Biocontrol Activity of Debaryomyces hansenii Against Spoilage Molds in Synthetic and Meat-Derived Media" Journal of Fungi 11, no. 9: 681. https://doi.org/10.3390/jof11090681
APA StyleRuiz-Castilla, F. J., Pérez-Fernández, A. L., Villamagua-Rojas, P. I., Chacón-Navarrete, H., & Ramos, J. (2025). Assessing the Biocontrol Activity of Debaryomyces hansenii Against Spoilage Molds in Synthetic and Meat-Derived Media. Journal of Fungi, 11(9), 681. https://doi.org/10.3390/jof11090681

